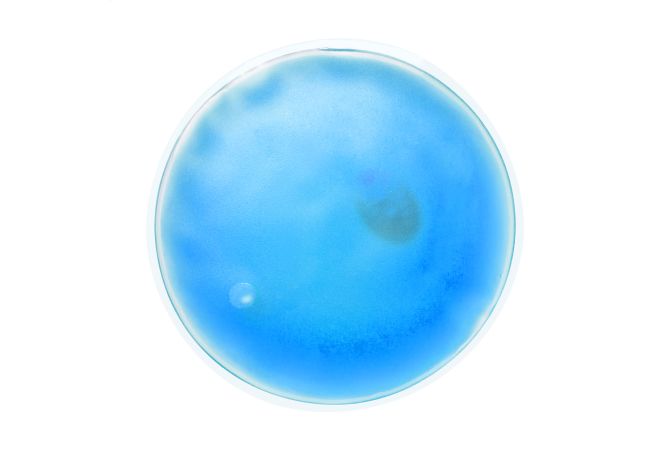
main product photo

Gestionăm în mod prietenos prezența ta pe website-ul PROMER®!
Datele privind navigarea ta pe website sunt adunate sub formă de cookies. Aceste informații sunt folosite strict pentru a-ți oferi o experiență personalizată cât mai apropiată de nevoile tale.
Pentru mai multe detalii, poți accesa pagina dedicată privind politica de cookies
Pentru mai multe detalii, poți accesa pagina dedicată privind politica de cookies
Setează preferințele
-
Cookie-uri necesare/esențiale
* nu poate fi dezactivat -
Cookie-uri de funcționalitate
-
Cookie-uri de urmărire și performanță
-
Cookie-uri de direcționare și publicitate
Citește mai multe despre datele de tip cookies